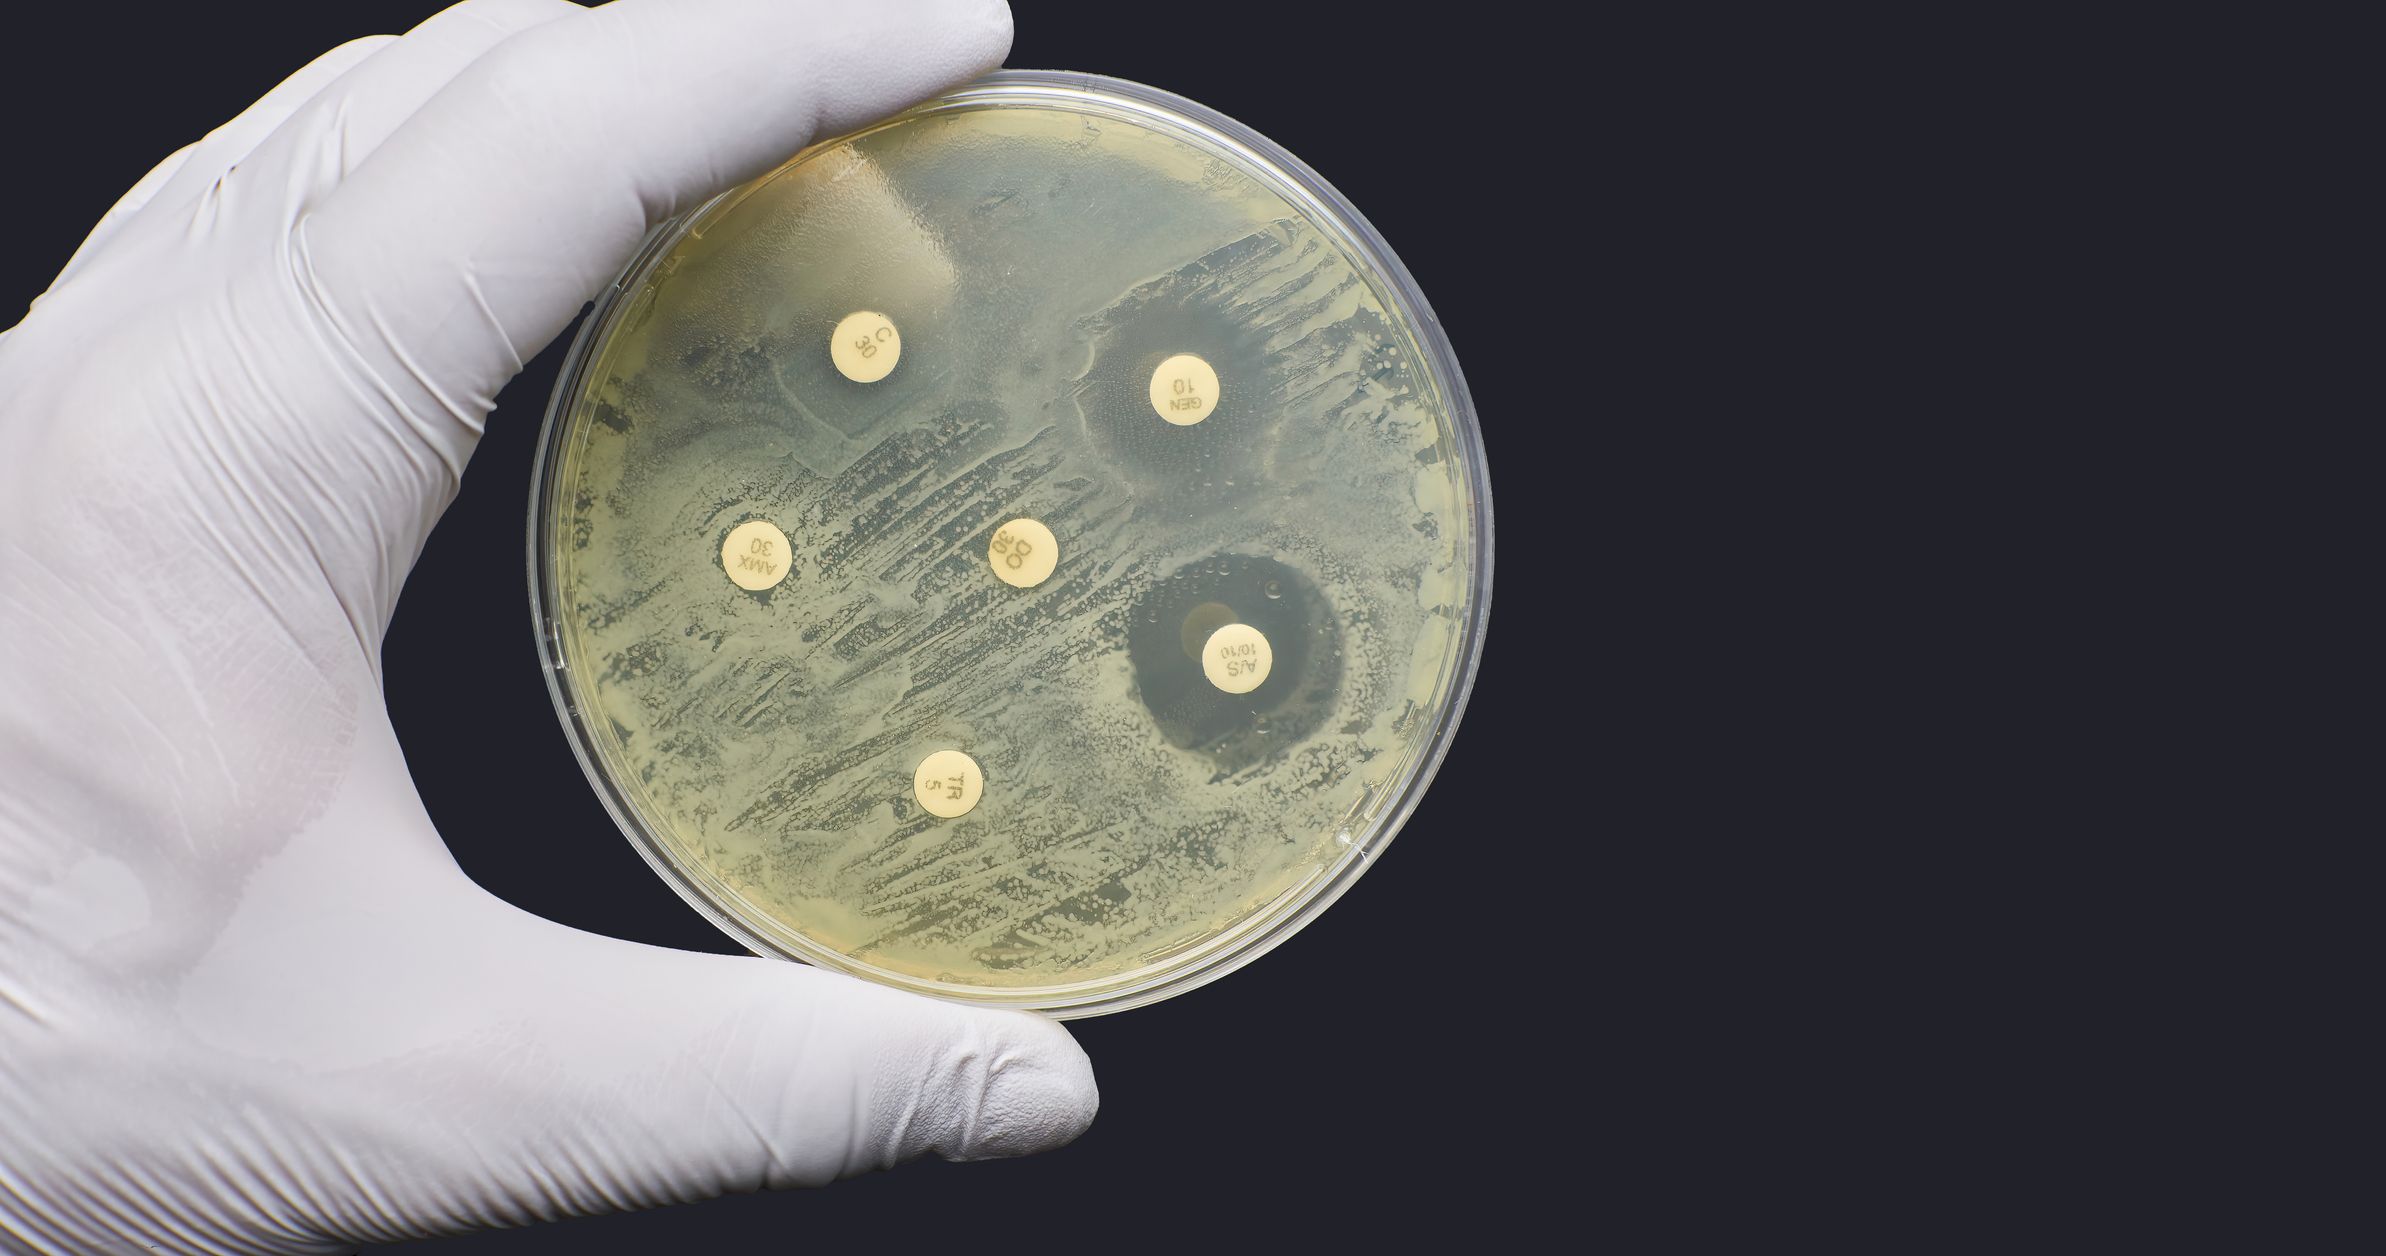
A petri dish with drug resistant bacteria on it

Pollution and Contamination
A Watery Soup
Outside of a laboratory, water is never completely pure. Water easily picks up impurities like calcium, iron and silt as it filters through rocks and soil. The very property that makes water so useful in our bodies for transporting nutrients makes drinking water a potential source of harm.
Globally, two billion people drink unsafe water. Pollution comes from human sources. Faecal matter from households, heavy metals from industry, and nitrates from agricultural runoff are just a few. Contamination can come from natural sources, such as arsenic in soils. Testing the water to understand and treat the problem, or switching to a different source altogether, are the best defences against unsafe water.

A Deadly Cocktail
A glass of crystal-clear water can be anything but clean. Bacteria, parasites, and household, industrial and agricultural waste can be invisible to our eyes.
Detecting dirty water is the first step to fair water access in places where industry competes with communities for water, where wastewater control is inadequate, or where seasonal variations can change the quality of water.
Solid waste blocks pipes and adds to toxic microplastic pollution in water.

Oil spills and road runoff can form a barrier that stops oxygen reaching wildlife.

Arsenic is released into groundwater from underground soils and gravels and is toxic even in small quantities.

Nitrogen and phosphate from fertilisers and manure cause algal blooms in rivers and lakes, which reduces oxygen levels.

Water draining from mines can be highly acidic and contain copper and iron which can kill wildlife.

Pesticides are washed into water bodies from fields, killing wildlife.

Pharmaceuticals, like antibiotics, end up in waterways where they can affect wildlife and contribute to drug resistance.
Bacteria and viruses come from untreated sewage and can make wildlife and humans ill.

Governments walk a tightrope of difficult decisions: to encourage industry and hope that local employment helps communities to become wealthier; or to control industry, protect water sources and environments, and risk losing investment.
Dhaka, Bangladesh
Dhaka is home to 10.2 million people and the world's greatest concentration of textile manufacturers. Dhaka's water faces a triple threat from household waste, industrial pollution and naturally occurring arsenic that leaches into groundwater from soils surrounding the city. The city also has a monsoon climate which alternately floods and dries out the city. Dhaka's residents rely on groundwater for drinking water, but many of the residents use the rivers for washing, bathing, and fishing.

Water Collection and Use in Bangladesh

Kolshi
These traditional water pitchers are widely used in Bangladesh for carrying and storing water. Aluminium kolshis are tough and can withstand daily wear and tear, and more traditional kolshis made of porous ceramics have an evaporative cooling effect that can keep the water relatively cool. The bulbous shape is designed to be easily gripped and carried when full of heavy water.

Water bucket
Standing water, like wet season puddles, is a perfect breeding ground for mosquitos. Dry conditions, when people are most likely to store water in open vessels, can see peaks in outbreaks of dengue fever, Zika, and other diseases transmitted by mosquitos. Water storage buckets like the one here, have tight-fitting lids and a tap at the bottom to stop mosquitos from entering and laying eggs.

Gamcha
In hot, tropical countries, a piece of clothing to protect against the sun, heat and biting insects is a must. Gamchas are long adaptable rectangles of cloth that can be worn in different ways: as a headscarf, a shawl, or a loincloth, or dipped in water and draped around the neck to keep the wearer cool. Many gamchas, like this one, have checked or striped patterns and bright colours.

Garments
These neatly folded and plastic-bagged garments have been made in Dhaka. Around 4 million people are employed in producing garments like these in Bangladesh, in dying fabrics, tanning leather, milling and sewing. Denim is dyed using synthetic indigo that pollutes the environment if wastewater is released without treatment.



Monsoon Season in Dhaka (May–September)
1. Dhaka is flooded by monsoon rainwater from the upstream Ganges-Meghna-Brahmaputra basin. The river swells, the pollutants are diluted, and the water looks lighter in colour.
2. Many locals use the river water at this time of year because it looks cleaner.
3. Although the water looks cleaner, floods wash household waste like sewage into the river and tubewells around the city. Disease risk is higher at this time of year.
Dry Season in Dhaka (October–April)
Household and industrial waste are released into the river. Less than 15% of household waste is treated before release.
1. The river has less water in it and the concentrated water looks dark brown and visibly dirty. Heavy metal pollutants are a serious problem at this time of year.
2. Locals avoid using the river water during the dry season because it looks dirty.
Mapping Quality
To solve the problem, we need to see the problem. Testing water quality and mapping water toxicity levels through space and time help everyone to plan actions like river clean-ups and water collection for agriculture.
The sooner that water quality problems can be detected and communicated, the less likely people are to be exposed to polluted and contaminated water.
Measuring water quality around Dhaka has shown us that the rivers and pools around the city are cleanest just after the monsoon, when the water levels are still high but flooding has stopped.
Aquatic animals in Bangladesh
Bangladesh is a country rich in rivers. Rain and meltwater flow from the Himalayan mountains in the north out to sea via the world's largest floodplain. The summer monsoons bring heavy downpours and a warmer climate brings more tropical cyclones from the ocean which regularly flood the delta. Ecosystems across Bangladesh have evolved to thrive in a water-filled world and are left clinging on in a polluted and warmer future.
Managing to be clean
More than 1.5 million handpumps in Bangladesh do not work. Building water infrastructure like handpumps and boreholes is easy, the real challenge is keeping the water clean and flowing so that everyone has a dependable source to use.
Testing the water supply regularly, and creating an affordable maintenance plan for infrastructure like handpumps, ensures that problems are spotted and fixed before people are badly affected. The effect of a good water source on quality of life is profound: people live healthier lives, complete their education and grow businesses that support themselves and communities.

The SafePani project in Bangladesh uses professional service providers to maintain infrastructure and keep water supply at schools and healthcare centres reliable and clean.
The SafePani project in Bangladesh uses professional service providers to maintain infrastructure and keep water supply at schools and healthcare centres reliable and clean.